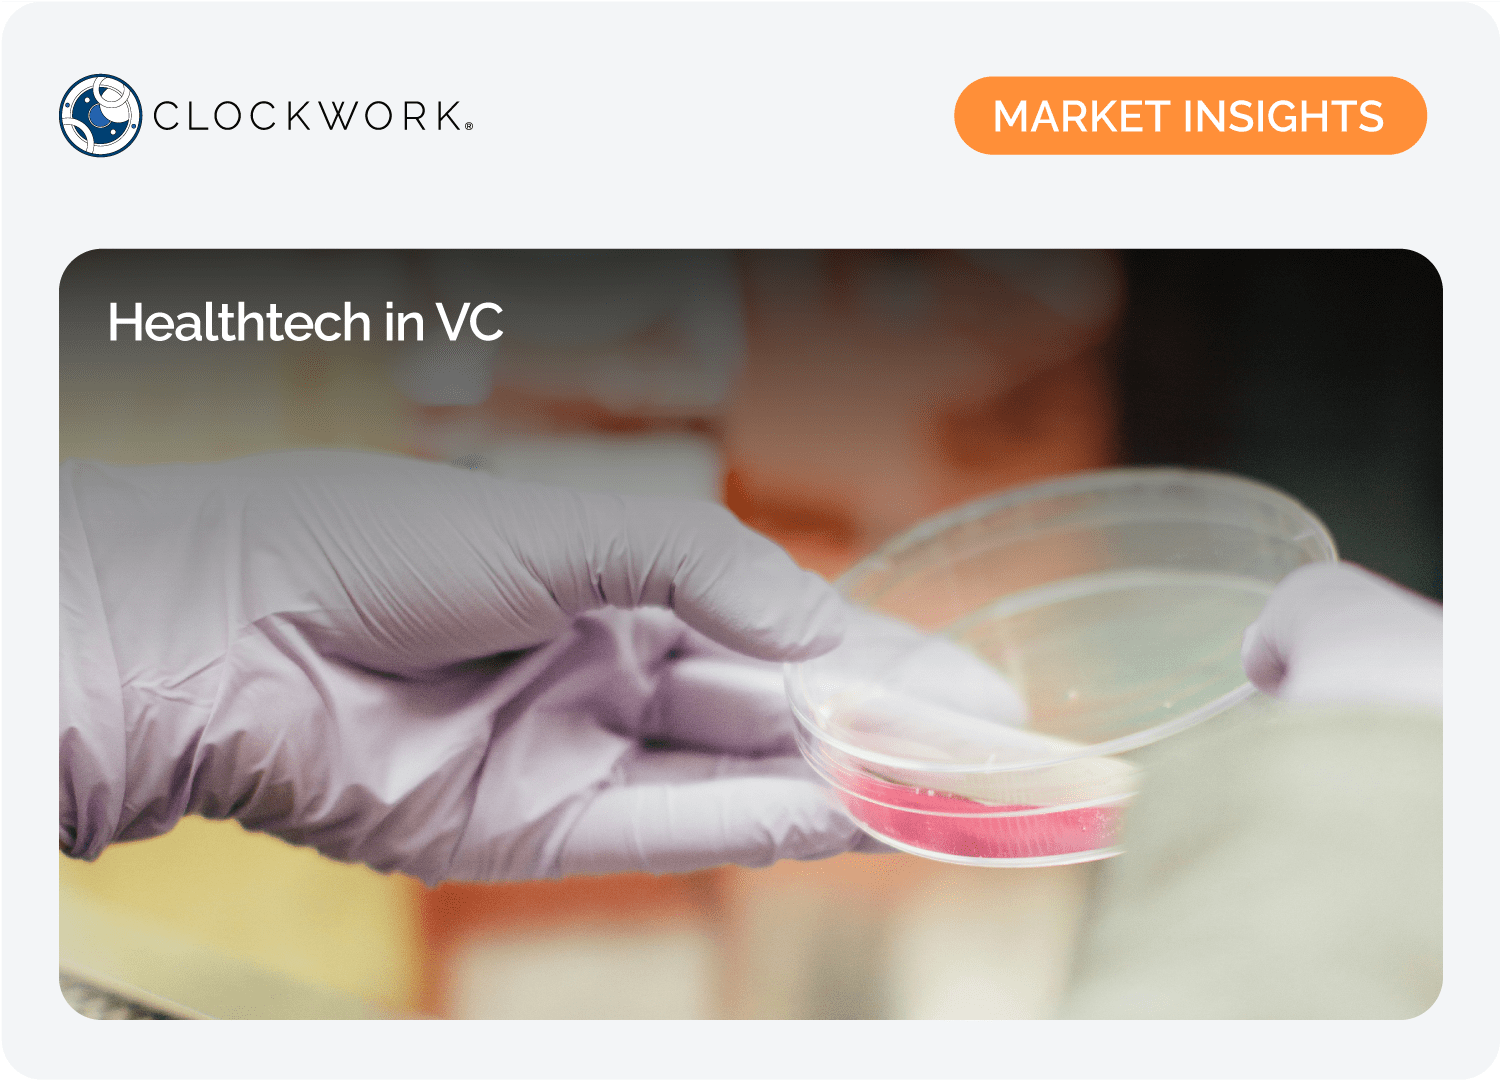

Welcome to the Clockwork community!
We’re excited to have you here and grateful you’ve chosen to access our growing library of curated insights, reports, and trends. It’s our mission to support your growth by providing clarity and transparency into the private investment ecosystem.
Welcome to intelligent private investing!
Insights on market trends, investment strategies, and emerging sectors within private markets.
January PMI – Norway’s Sovereign Wealth Strategy and Preparing for Q-Day
An examination of Norway’s sovereign wealth strategy and pragmatic climate transition investing. Separately, an analysis of post-quantum cryptography, Q-Day, and…
October PMI – The Private Equity S&P, Plus AI’s railroad problem
The launch of the S&P Private Equity 50 benchmark, addressing private equity performance measurement. Plus, challenges in AI infrastructure investments.
August Private Market Intelligence
Private credit benefits from a tax rule change boosting deductibility, while banks reclaim market share with tightening spreads. Fintech shifts focus to…
April 25 Private Markets Intelligence
Private market dynamics show LP distributions surpassing contributions for the first time since 2015, while green investments prioritize proven technologies amid…
March 25 Private Markets Intelligence
Investors are exploring innovative alternatives in private markets, from tokenized assets to AI-backed investments. LATAM's VC scene, led by Brazil, sees rapid…
February 25 Private Markets Intelligence
Climate Tech Investing in a DeepSeek World, is your portfolio home-biased? The private credit ETF is here.
January 25 Private Markets Intelligence
Private credit trends, market access and new policy impacts.
November ’24- Private Markets Intelligence
Venture capital funding heavily favors AI, with substantial growth and high valuations, while non-AI sectors struggle. Carbon credit markets are expanding…
October 24 Private Markets Intelligence
Read our latest Private Markets Intelligence Report, featuring insights on: The Great Wealth Transfer, Private Credit and US Elections
July 24 Private Markets Intelligence
Venture Capital Activity, Private Equity Surge and sector highlights.
June 24 Private Markets Intelligence
Overall fundraising stability trends, investment stage shifts, and private credit market growth
May 2024 Private Market Intelligence
Learn about the rising role of private credit amid higher interest rates and market volatility.
April 24 Private Market Intelligence
Dive into insights on the interest rate cycle, startup resilience, private markets in 2024, and more.
Visual snapshots and comprehensive analyses of specific industries that simplify complex topics, highlighting key trends and relevant data.
The Swiss System
A system shaped by policy and incentives has made Switzerland one of the most capital-efficient economies, driving liquidity, diversification, and long-term wealth creation.
How Geopolitics Is Reshaping Global Markets
As conflicts rise and trade routes come under pressure, geopolitical risk is reshaping global markets through higher defense spending, supply chain shifts, and inflation volatility.
Art as an Alternative Investment
More than a passion asset, art functions as a real asset alternative, offering diversification, value preservation, and distinct liquidity and planning dynamics within private…
Co-Investing vs. Direct Investing: An Overview
Co-investing and direct investing are reshaping private market participation, offering investors lower fees, greater control, and access to high-quality opportunities as LPs…
ABF, Private Credit and what it means for investors
Asset-Based Finance is emerging as private credit’s next growth engine, offering investors diversification, downside protection, and a complexity premium across consumer,…
ABF Infographic
Asset-Based Finance is emerging as private credit’s next growth engine, offering investors diversification, downside protection, and a complexity premium across consumer,…
Chasing Liquidity
Secondaries surged to $152 billion in 2024 as LPs seek liquidity and GP-led deals approach parity. Pricing improved in buyout and infrastructure while venture stayed volatile.…
Climate Tech
Climate tech outpaced U.S. VC from 2020 to 2023, then slowed in 2024 amid uncertainty. Despite capital intensity and short runways, forecasts see 25% CAGR through 2029 with EU support.
Fundraising Overview
PE fundraising has fallen since 2021. In 2024, pace sits 20 percent below 2023. Capital concentrates with experienced managers, launches decline, geopolitical risk tops concerns,…
PE Exits
Exits remain scarce despite rising values. 2024 outpaces 2023 in dollars yet trails decade norms. High rates and valuation gaps slow deals, extend holding periods, and push…
The Great Wealth Transfer
A overview of the Great Wealth Transfer as $84.4 trillion shifts through 2045, reshaping investor preferences toward alternatives and expanding private markets while public…
Alternative Investments
Alternatives snapshot: rapid AUM growth, distinct strategy objectives, higher allocations for institutions and endowments, and implied real returns led by private equity versus…
Tokenization
Asset tokenization is moving from pilots to mainstream as regulation and infrastructure mature, with real estate and debt leading adoption and market size projected to reach…
Infrastructure Investment Snapshot
Infrastructure is gaining investor appeal amid a funding gap, digitalization, and decarbonization, with AUM growth outpacing other private assets despite a 2023 fundraising…
Healthtech in VC
Healthtech VC cooled since 2021 yet remains significant. Funding centers on provider workflow tools. Bay Area leads. Exits slowed in 2023, while AI progress supports continued…
US Real Estate
Real estate provides income and diversification as cap rates stabilize relative to bonds, sector dynamics diverge, and U.S. rental yields and data center demand highlight…
ESG Investing
An investor primer on ESG in private markets covering materiality, integration across PE, VC, and credit, diligence and value creation levers, reporting frameworks, and…
Artificial Intelligence in Venture Capital
How AI reshapes venture capital across sourcing, diligence, and portfolio support. Tools, data advantages, and risks.
Private Credit Trends
Private credit is expanding globally, it has outperformed traditional fixed income, attracts pension funds and family offices, and stays resilient despite fundraising volatility…
2023 IPO Market
IPO activity remains subdued after 2022’s freeze, with modest reopening in 2023. Tech and healthcare lead limited deals. Proceeds and counts trail prior years, and post-IPO…
2023 US Private Markets
U.S. private markets cooled in 2023, with VC rounds shrinking, capital concentrating in health, enterprise software, and fintech, while private credit gained traction and green…
FDA Medical Devices Approval Process
Understand the FDA drug approval process with a guide to regulatory pathways, INDs, clinical trial phases, timelines, costs, success rates, and expedited programs that accelerate…
Biannual comprehensive analyses of key events from the past months, exploring their impact on private markets and alternative investments.
Summer 25 Solstice Report
The Summer Solstice Report is the second edition of Clockwork’s biannual, high-signal briefing for asset owners, institutional investors, family offices, and private capital allocators.
Winter 24 Solstice Report
Critical trends and predictions to guide your 2025 investment strategy in private markets.